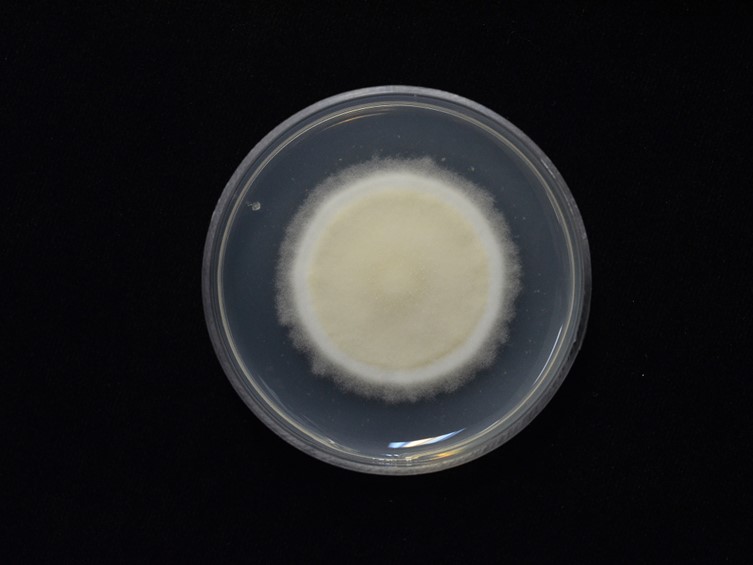

Holotype:
THAILAND, Nakhon Ratchasima Province, Pak Chong District, Khao Yai National Park, Mo Sing To nature trail, 10 Dec. 2009, A. Khonsanit, K. Tasanathai, M. Sudhadham, P. Srikitikulchai, R. Ridkaew, S. Mongkolsamrit & T. Chohmee, holotype BBH27326, ex-type living culture BCC40756
Habitat:
Underside of a dicotyledonous leaf
Host:
Adult moth (Pyralidae)
Description:
Asexual morph:  White mycelium covering the body of the host.
Conidiophores mononematous, smooth-walled, hyaline, with
single phialide. Phialides elongate-ampulliform, smooth-walled,
hyaline, 4–27 × 1−3 µm. Conidia 1-celled, narrowly
fusiform, smooth-walled, hyaline, 4–13 × 1−2 µm.
Sexual morph: Specimens found on adult moths (Pyralidae),
on the underside of dicotyledonous leaves, white mycelium
covered on the host body.
White mycelium covering the body of the host.
Conidiophores mononematous, smooth-walled, hyaline, with
single phialide. Phialides elongate-ampulliform, smooth-walled,
hyaline, 4–27 × 1−3 µm. Conidia 1-celled, narrowly
fusiform, smooth-walled, hyaline, 4–13 × 1−2 µm.
Sexual morph: Specimens found on adult moths (Pyralidae),
on the underside of dicotyledonous leaves, white mycelium
covered on the host body.  Perithecia superficial, scattered on
the host body, ovoid, strong orange (26A), light orange yellow
, light yellowish pink, 580−640 × 170−210 µm.
Perithecia superficial, scattered on
the host body, ovoid, strong orange (26A), light orange yellow
, light yellowish pink, 580−640 × 170−210 µm.  Asci
cylindrical, hyaline, 302–450 × 4−5 µm. Asci-caps
abrupt cone-shaped, hyaline, 4.5−5.5 × 4−5 µm. Ascospores
filiform, multi-septate, breaking into part-spores, hyaline. Part spores cylindrical, hyaline, 5–18 × 1 µm.
Asci
cylindrical, hyaline, 302–450 × 4−5 µm. Asci-caps
abrupt cone-shaped, hyaline, 4.5−5.5 × 4−5 µm. Ascospores
filiform, multi-septate, breaking into part-spores, hyaline. Part spores cylindrical, hyaline, 5–18 × 1 µm.
Culture characteristics:
Colony on PDA cottony, convex to the agar surface, entire margin, attaining a diam of
30–32 mm in 20 d, white. Conidia and reproductive structures are not observed on both media after
30 d of incubation at 25 °C
Colony on PDA cottony, convex to the agar surface, entire margin, attaining a diam of
30–32 mm in 20 d, white. Conidia and reproductive structures are not observed on both media after
30 d of incubation at 25 °C
Reference:
A. Khonsanit, D. Thanakitpipattana, S. Mongkolsamrit, et al. (2024). A phylogenetic assessment of Akanthomyces sensu lato in Cordycipitaceae (Hypocreales, Sordariomycetes): introduction of new genera, and the resurrection of Lecanicillium. Fungal Systematics and Evolution14:271–305.
DOI: https://doi.org/10.3114/fuse.2024.14.17Species |
Strain |
Compound |
Pubchem CID |
Biological activity |
Reference |
|---|
|
Strain |
- |
|---|---|
| BCC 40756T | - |